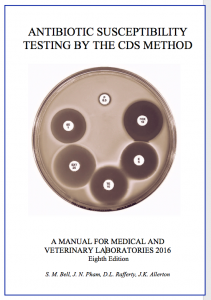

Archives
The archives contain ASM Presentations from the CDS team, links to current and previous versions of the CDS manual, all newsletters, slide collections and most other CDS publications. Note: All files on this page are in pdf format. To access an archived manual or publication click the appropriate icon on left of screen.
PREVIEW of QA (CDS Manual 9th Edition)
TABLE 3.1
Tables 11.3
ASM
ASM 2019 Rafferty, Allerton and James Presentations
ASM 2018 Rafferty, Allerton and James Presentations
ASM 2017 Rafferty and Allerton Presentations
ASM 2016 Rafferty, Allerton and Newton Presentations
ASM 2015 Bell, Newton and Rafferty’s Presentations
ASM 2014 Bell, Hanrahan and McIver’s Presentations
ASM 2013 JP Jeanette’s presentation
ASM 2013 TN Thanh’s presentation
ASM 2013 Newton’s presentation
ASM 2012 Final Bell & Pham’s Presentations
ASM 2011 Bell & Pham’s Presentations
ASM 2010 CDS Team’s Presentation
ASM 2009 CDS Team’s Presentation
ASM 2008 CDS Team’s Presentation
ASM 2008 CDS Handout
Blood Culture Direct Sens Poster
Urine Direct Sens Poster
ASM 2011 Measurement Uncertainty- Andrew Bowen
Manuals
|
Antibiotic Susceptibility Testing By The CDS Method
(Eighth Edition)
March 2017 |
 |
Antibiotic Susceptibility Testing By The CDS Method
(Seventh Edition)
December 2013
|
 |
Antibiotic Susceptibility Testing By The CDS Method
(Sixth Edition)
September 2011 |
 |
Antibiotic Susceptibility Testing By The CDS Method
(Fifth Edition)
2010
|
 |
Antibiotic Susceptibility Testing By The CDS Method
(Fourth Edition)
2006 |
 |
Antibiotic Susceptibility Testing By The CDS Method
(Third edition)
2004 |
 |
Antibiotic Susceptibility Testing By The CDS Method
(Second edition)
2002 |
 |
Antibiotic Susceptibility Testing By The CDS Method
(First edition)
1999 |
Publications
 |
Calibration of Ceftolozane-tazobactam for the CDS test
Dianne Rafferty, Julie Allerton, Pratibha Malini James, Sydney Bell
Poster: 2019 ASM Annual Conference in Adelaide.
|
 |
Calibrated Dichotomous Susceptibility Disc Testing of Polymyxin B: A Review
Julie Allerton, Dianne Rafferty, Pratibha Malini James, Sydney Bell
Poster: 2019 ASM Annual Conference in Adelaide.
|
 |
Evaluation of CDS disc test and Thermo Fisher SensititreTMbroth microdilution method against reference ISO broth micro dilution for Enterobacteriaceae species
Pratibha Malini James, Dianne Rafferty, Julie Allerton, Sydney Bell
Poster: 2019 ASM Annual Conference in Adelaide.
|
 |
A review of Polymyxin Disc Testing from a CDS Perspective
Julie Allerton, Dianne Rafferty, Pratibha Malini James and Sydney Bell
Poster: 2018 ASM Annual Conference in Brisbane.
|
 |
A Comparison of MICs Determined by CDS, CLSI & EUCAST Reference techniques.
Julie Allerton, Dianne Rafferty, Pratibha Malini James and Sydney Bell
Poster: 2018 ASM Annual Conference in Brisbane.
|
 |
Maintenance of Microbiological Reference Culture Collections (MRCC)
|
 |
A Comparison of the Results of Three Methods of MIC Determination
Julie Allerton, Dianne Rafferty, Pratibha Malini James and Sydney Bell
Poster: 2018 RCPA Pathology Update
|
 |
The CDS Antibiotic Susceptibility Test Method : Fulfilling a Need.
Bell, Pham , Newton and Nguyen
|
 |
Detection of carbapenemase enzymes in Enterobacteriaceae by the CDS.
A short article by S. M. Bell and J.J Pham.
Extracted from Breakpoint 2013 – 5 with the kind permission of the editor Sharon Chen.
|
 |
Calibration of Doxycycline for use in urinary
tract infections with enterococci. Pathology 2012, 44(7) pp. 654
Sydney Bell, Jeanette Pham, Jawad Saab, Thanh Nguyen
|
 |
Improved growth of VRE on Chrom VRE Agar by Incubation in 5% CO2
Varuna Navaratne, Sydney Bell and Jeanette Pham
|
 |
Performance of a Disposable Plastic Inoculating
Needle in the Preparation of the CDS Inoculum
Presentation at the ASM Annual Conference in Gold Coast, 2006.
|
 |
Direct Sensitivity Testing of Urine Samples
Presentation at the ASM Annual Conference in Canberra, 2005.
|
 |
Evaluation of Direct Susceptibility Testing of Positive Broth Blood Cultures
Sue Mahrer, Porl Reinbott and Sydney Bell
|
|

|
Field trial of Testing Enterococci
This is an interesting study of the performance by CDS users in susceptibility testing of enterococci to ampicillin and vancomycin.
|
 |
Calibration of Cefoxitin and Staph. aureus
Presentation at ASM Annual Conference in Sydney, 2004
Bell, S.M., Gatus, B.J., Pham, J.N., Rafferty, D.L., & Dimon, M |
 |
Additions and Modifications
S. M Bell
A technical note entitled ‘Additions and Modifications to the Range of Antibiotics Tested by the CDS Method of Sensitivity Testing’, published by “Pathology” (1988, 20, 303‑304).
|
 |
Update of the CDS Sensitivity Test
The Microbiology Clinical Update Program edited by Nerissa Lee published an Update of the CDS Sensitivity Test in 1984. In this publication we undertook a major revision of the test and extended the method to test those antibiotics which had been developed since the original modification was published.
|
 |
Mechanisms of Ampicillin Resistance of H. influenzae isolated from the Respiratory Tract.
Bell and Plowman
First description of inherent resistance to Ampicilin of H. influenzae. Published in Lancet, Feb, 1980
|
 |
The CDS Monograph
The CDS Monograph which was published as a Supplement by “Pathology” in 1975. The Monograph contains a basic description of the method and explains how each step of the procedure was developed and tested.
|
Newsletters
NL_38 Summary of Changes in 8th edition
NL_37 Newsletter ASM Workshop 201 Report
NL_36 Newsletter ASM Workshop 2015 Report
NL_35 Newsletter 35 Proceedings of ASM 2013 Report
NL_34 Calibration of Co-trimoxazole, anaerobes and unusual organisms
NL_33 Calibration of Ceftaroline
NL_32 Disc Testing Nocardia
NL_31 Doxycycline and Enterococci
NL_30 New Faces
NL_29 N.gonorrhoeae update
NL_28 Fosfomycin, Timentin, Ticarcillin, Staph. Sp
NL_27 Enterococci & Tetracyclines
NL_26 Modifications of CDS Method in 2011
NL_25 Modifcation of CDS Method in 2010 (1)
NL_24 Modifcation of CDS Method in 2010 (2)
NL_23 CDS ASM 2010 Workshop Report
NL_22 Doripenem, Campylobacter and Tetracycline
NL_21 Metallo-ßlactamases
NL_20 Tigecycline, Fluroquinolones and Vet Labs
NL_19 Corrections CDS Manual 4th Ed.
NL_18 N/A
NL_17 CDS ASM 2005 Report
NL_16 N/A
NL_15 N/A
NL_14N/A
NL_13 Testing Staphylococci
NL_12 CDS ASM 2003 Report
NL_11 CDS ASM 2001 Report
NL_10 CDS ASM 2000 Report
NL_9 CDS ASM 1997 Report
NL_8 H. influenzae, Strep. pneumoniae, Change to tables
NL_7 CDS ASM 1995 Report
NL_6 CDS ASM 1993 Report
NL_5 CDS ASM 1992 Report
NL_4 Media Q A problems, table reformat
NL_3 CDS ASM 1991 Report
NL_2 CDS Method – major changes
NL_1 CDS Reference Laboratory
Teaching slides
Clindamycin Testing Erythromycin against Staphs and Strepts
Cefoxitin Testing Staph. aureus against Cefoxitin
MBL Detection of MBL mediated resistance